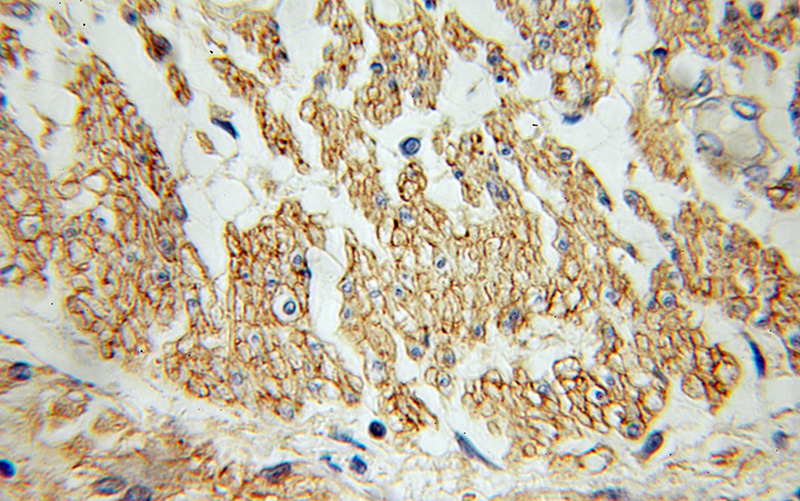
Immunohistochemical of paraffin-embedded human colon cancer using Catalog No:108097(ANXA6 antibody) at dilution of 1:100 (under 40x lens)

-
Product Name
Annexin VI antibody
- Documents
-
Description
Annexin VI Rabbit Polyclonal antibody. Positive IHC detected in human colon cancer tissue. Positive IP detected in mouse kidney tissue. Positive WB detected in HeLa cells, human brain tissue, Jurkat cells, mouse brain tissue, mouse kidney tissue, mouse placenta tissue. Observed molecular weight by Western-blot: 67 kDa
-
Tested applications
ELISA, IHC, WB, IP
-
Species reactivity
Human,Mouse,Rat; other species not tested.
-
Alternative names
67 kDa calelectrin antibody; Annexin 6 antibody; annexin A6 antibody; Annexin VI antibody; ANX6 antibody; ANXA6 antibody; Calphobindin II antibody; CBP68 antibody; Chromobindin 20 antibody; CPB II antibody; LipOCortin VI antibody; p68 antibody; p70 antibody; Protein III antibody
-
Isotype
Rabbit IgG
-
Preparation
This antibody was obtained by immunization of Annexin VI recombinant protein (Accession Number: NM_001155). Purification method: Antigen affinity purified.
-
Clonality
Polyclonal
-
Formulation
PBS with 0.1% sodium azide and 50% glycerol pH 7.3.
-
Storage instructions
Store at -20℃. DO NOT ALIQUOT
-
Applications
Recommended Dilution:
WB: 1:500-1:5000
IP: 1:200-1:2000
IHC: 1:20-1:200
-
Validations

HeLa cells were subjected to SDS PAGE followed by western blot with Catalog No:108097(ANXA6 Antibody) at dilution of 1:1000

IP Result of anti-ANXA6 (IP:Catalog No:108097, 4ug; Detection:Catalog No:108097 1:500) with mouse kidney tissue lysate 4000ug.
Immunohistochemical of paraffin-embedded human colon cancer using Catalog No:108097(ANXA6 antibody) at dilution of 1:100 (under 40x lens)
-
Background
ANXA6, also called CBP68, or 67 kDa calelectrin, belongs to a family of calcium-dependent membrane and phospholipid binding proteins. Several members of the annexin family have been implicated in membrane-related events along exocytotic and endocytotic pathways. The annexin VI gene is approximately 60 kbp long and contains 26 exons. It encodes a protein of about 68 kDa that consists of eight 68-amino acid repeats separated by linking sequences of variable lengths. It is highly similar to human annexins I and II sequences, each of which contain four such repeats. Annexin VI has been implicated in mediating the endosome aggregation and vesicle fusion in secreting epithelia during exocytosis.
-
References
- Jia X, Yin L, Feng Y. A dynamic plasma membrane proteome analysis of alcohol-induced liver cirrhosis. Proteome science. 10(1):39. 2012.
Related Products / Services
Please note: All products are "FOR RESEARCH USE ONLY AND ARE NOT INTENDED FOR DIAGNOSTIC OR THERAPEUTIC USE"
